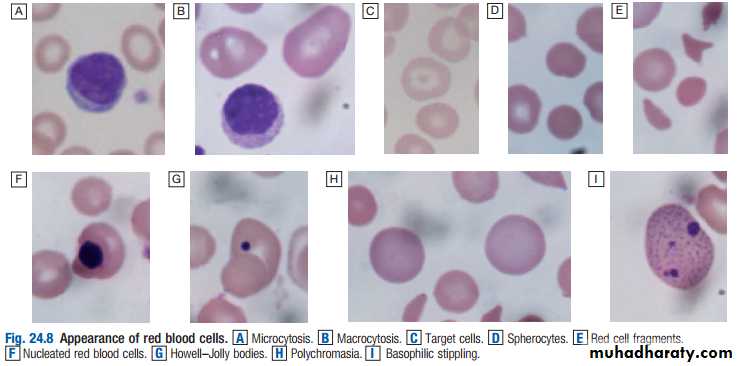

ANEMIA
Haematopoiesis describes the formation of blood cells, an active process that must maintain normal numbers of circulating cells and be able to respond rapidly to increased demands such as bleeding or infection., in adults, normal haematopoiesis is restricted to the vertebrae, pelvis, sternum, ribs, clavicles, skull, Structural organisation of normal bone marrow. Megakaryocyte Bony trabecula Neutrophil Erythroid 'nest' Vascular sinusoid Fat cell Myelocyte Blast cells and progenitor cells Lymphocyte humeri and proximal femora. However, red marrow can expand in response to increased demands for blood cells.
Bone marrow contains a range of immature haematopoietic precursor cells and a storage pool of mature cells for release at times of increased demand.
All blood cells are derived from pluripotent haematopoietic stem cells. These comprise only 0.01% of the total marrow cells, but they can self-renew (i.e. make more stem cells) or differentiate to produce a hierarchy of lineage-committed stem cells.
Red cell precursors formed in the bone marrow from the erythroid (CFU–E) progenitor cells are called erythroblasts or normoblasts.
RBC production needs intactact bone marrow,iron vitamines & erythropoetine.
Normal mature red cells circulate for about 120 days. They are 8 µm biconcave discs lacking a nucleus but filled with haemoglobin, which delivers oxygen to the tissues. In order to pass through the smallest capillaries, the red cell membrane is deformable
the energy for these functions is provided by anaerobic glycolysis and the pentose phosphate pathway in the cytosol. The ABO and Rhesus systems are the most commonly recognised
Haemoglobin is a protein specially adapted for oxygen transport. It is composed of four globin chains, each surrounding an iron-containing porphyrin pigment molecule termed haem. Globin chains are a combination of two alpha and two non-alpha chains; haemoglobin A (αα/ββ) represents over 90% of adult haemoglobin, whereas haemoglobin F (αα/γγ) is the predominant type in the fetus. Each haem molecule contains a ferrous ion (Fe2+ ), to which oxygen reversibly binds; the affinity for oxygen increases as successive oxygen molecules bind
Red cells at the end of their lifespan of approximately 120 days are phagocytosed by the reticulo-endothelial system. Amino acids from globin chains are recycled and iron is removed from haem for re-use in haemoglobin synthesis. The remnant haem structure is degraded to bilirubin and conjugated with glucuronic acid before being excreted in bile. In the small bowel, bilirubin is converted to stercobilin; most of this is excreted, but a small amount is reabsorbed and excreted by the kidney as urobilinogen. Increased red cell destruction due to haemolysis or ineffective haematopoiesis results in jaundice and increased urinary urobilinogen. Free intravascular haemoglobin is toxic and is normally bound by haptoglobins, which are plasma proteins produced by the liver.
INVESTIGATION OF DISEASES OF THE BLOOD
The full blood count: To obtain a full blood count (FBC), anticoagulated blood is processed through automated blood analysers which use a variety of technologies (particle-sizing, radiofrequency and laser instrumentation) to measure the haematological parameters. These include numbers of circulating cells, the proportion of whole blood volume occupied by red cells (the haematocrit, Hct), and the red cell indices which give information about the size of red cells (mean cell volume, MCV) and the amount of haemoglobin present in the red cells (mean cell haemoglobin, MCH). Blood analysers can differentiate types of white blood cell and give automated counts of neutrophils, lymphocytes, monocytes, eosinophils and basophilsBlood film examination: done by hematologist to analyse the abnormal component that might present .
Bone marrow examination: In adults, bone marrow for examination is usually obtained from the posterior iliac crest. After a local anaesthetic, marrow can be sucked out from the medullary space, stained and examined under the microscope (bone marrow aspirate).
Anaemia :
Anaemia refers to a state in which the level of haemoglobin in the blood is below the reference range appropriate for age and sex. The clinical features of anaemia reflect diminished oxygen supply to the tissues.A rapid onset of anaemia (e.g. due to blood loss) causes more profound symptoms than a gradually developing anaemia. Individuals with cardiorespiratory disease are more susceptible to symptoms of anaemia
Iron deficiency anaemia:
is the most common type of anaemia worldwide. A thorough gastrointestinal history is important, looking in particular for symptoms of blood loss. Menorrhagia is a common cause of anaemia in pre-menopausal females, so women should always be asked about their periods.• A dietary history should assess the intake of iron and folate, which may become deficient in comparison to needs (e.g. in pregnancy or during periods of rapid growth
• Past medical history may reveal a disease which is known to be associated with anaemia, such as rheumatoid arthritis (anaemia of chronic disease), or previous surgery (e.g. resection of the stomach or small bowel, which may lead to malabsorption of iron and/or vitamin B12).
• Family history and ethnic background may raise suspicion of haemolytic anaemias, such as the haemoglobinopathies and hereditary spherocytosis. Pernicious anaemia may also be familial.
• A drug history may reveal the ingestion of drugs which cause blood loss (e.g. aspirin and antiinflammatory drugs), haemolysis (e.g. sulphonamides) or aplasia (e.g. chloramphenicol).
Malabsorption :A dietary assessment should be made in all patients to ascertain their iron intake . Gastric acid is required to release iron from food and helps to keep iron in the soluble ferrous state, vitamine C improve iron absorption. Achlorhydria in the elderly or that due to drugs such as proton pump inhibitors may contribute to the lack of iron availability from the diet, as may previous gastric surgery. Iron is absorbed actively in the upper small intestine and hence can be affected by coeliac disease . At times of rapid growth, such as infancy and puberty, iron requirements increase and may outstrip absorption.
Investigations
Confirmation of iron deficiency: Plasma ferritin is a measure of iron stores in tissues and is the best single test to confirm iron deficiency. It is a very specific test. Ferritin levels can be raised in liver disease and in the acute phase response; in these conditions, a ferritin level of up to 100 µg/L may still be compatible with low bone marrow iron stores. Plasma iron and total iron binding capacity (TIBC) are measures of iron availability; hence they are affected by many factors besides iron stores.A transferrin saturation (i.e. iron/TIBC × 100) of less than 16% is consistent with iron deficiency but is less specific than a ferritin measurementManagement:
Unless the patient has angina, heart failure or evidence of cerebral hypoxia, transfusion is not necessary and oral. iron replacement is appropriate. Ferrous sulphate 200 mg 3 times daily (195 mg of elemental iron per day) is adequate and should be continued for 3–6 months to replete iron stores. The haemoglobin should rise by around 10 g/L every 7–10 days and a reticulocyte response will be evident within a week. A failure to respond adequately may be due to non-compliance, continued blood loss, malabsorption or an incorrect diagnosis. Patients with malabsorption or chronic gut disease may need parenteral iron therapyAnaemia of chronic disease (ACD) is a common type of anaemia, particularly in hospital populations. It occurs in the setting of chronic infection, chronic inflammation or neoplasia. The anaemia is not related to bleeding, haemolysis or marrow infiltration, is mild, with haemoglobin in the range of 85–115 g/L, and is usually associated with a normal MCV (normocytic, normochromic), though this may be reduced in long-standing inflammation. The serum iron is low but iron stores are normal or increased, as indicated by the ferritin or stainable marrow iron.
Diagnosis and management:
It is often difficult to distinguish ACD associated with a low MCV from iron deficiency. Examination of the marrow may ultimately be required to assess iron stores directly. A trial of oral iron can be given in difficult situations. A positive response occurs in true iron deficiency but not in ACD. Measures which reduce the severity of the underlying disorder generally help to improve the ACD.Megaloblastic anaemia:
This results from a deficiency of vitamin B12 or folic acid, or from disturbances in folic acid metabolism. Folate is an important substrate of, and vitamin B12 a co-factor for, the generation of the essential amino acid methionine from homocysteine. This reaction produces tetrahydrofolate, which is converted to thymidine monophosphate for incorporation into DNA. Deficiency of either vitamin B12 or folate will therefore produce high plasma levels of homocysteine and impaired DNA synthesis. The end result is cells with arrested nuclear maturation but normal cytoplasmic development: so-called nucleocytoplasmic asynchrony. All proliferating cells will exhibit megaloblastosis
The megaloblastic changes are most evident in the early nucleated red cell precursors, and haemolysis within the marrow results in a raised bilirubin and lactate dehydrogenase (LDH), but without the reticulocytosis characteristic of other forms of haemolysis. Iron stores are usually raised
The mature neutrophils show hypersegmentation of their nuclei, with cells having six or more nuclear lobes. If severe, a pancytopenia may be present in the peripheral blood. penia may be present in the peripheral blood. Vitamin B12 deficiency, but not folate deficiency, is associated with neurological disease in up to 40% of cases
Vitamin B12:
Vitamin B12 absorption: The average daily diet contains 5–30 µg of vitamin B12, mainly in meat, fish, eggs and milk – well in excess of the 1 µg daily requirement. Gastric acidity, parietal cells , pancreatic enzymes, all finally small intaestine, all partispate in B12 absorption.Causes of vitamin B12 deficiency:
Dietary deficiency: This only occurs in strict vegans but the onset of clinical features can occur at any age between 10 and 80 years. Less strict vegetarians often have slightly low vitamin B12 levels but are not tissue vitamin B12-deficient.
Gastric pathology : Release of vitamin B12 from the food requires normal gastric acid and enzyme secretion, and this is impaired by hypochlorhydria in elderly patients or following gastric surgery. Total gastrectomy invariably results in vitamin B12 deficiency within 5 years, often combined with iron deficiency; these patients need life-long 3-monthly vitamin B12 injections. After partial gastrectomy, vitamin B12 deficiency only develops in 10–20% of patients by 5 years; an annual injection of vitamin B12 should prevent deficiency in this group.
Pernicious anaemia: This is an organ-specific autoimmune disorder in which the gastric mucosa is atrophic, with loss of parietal cells causing intrinsic factor deficiency. In the absence of intrinsic factor, less than 1% of dietary vitamin B12 is absorbed.
Pancreatic diseases & small intestinal diseases also can lead to B12 deficiency.
Folate
Folates absorption are produced by plants and bacteria; hence dietary leafy vegetables (spinach, broccoli, lettuce), fruits (bananas, melons) and animal protein (liver, kidney) are a rich source.Management of megaloblastic anaemia:
The use of folic acid alone in the presence of vitamin B12 deficiency may result in worsening of neurological deficits.Vitamin B12 deficiency is treated with hydroxycobalamin 1000 µg IM for 6 doses 2 or 3 days apart, followed by maintenance therapy of 1000 µg every 3 months for life. The reticulocyte count will peak by the 5th–10th day after starting replacement therapy. The haemoglobin will rise by 10 g/L every week until normalised. The response of the marrow is associated with a fall in plasma potassium levels and rapid depletion of iron stores. If an initial response is not maintained and the blood film is dimorphic (i.e. shows a mixture of microcytic and macrocytic cells), the patient may need additional iron therapy. A sensory neuropathy may take 6–12 months to correct; long-standing neurological damage may not improve.
Folate deficiency: Oral folic acid 5 mg daily for 3 weeks will treat acute deficiency and 5 mg once weekly is adequate maintenance therapy. Prophylactic folic acid in pregnancy prevents megaloblastosis in women at risk, and reduces the risk of fetal neural tube defects . Prophylactic supplementation is also given in chronic haematological disease associated with reduced red cell lifespan (e.g. haemolytic anaemias). There is some evidence that supraphysiological supplementation (400 µg/day) can reduce the risk of coronary and cerebrovascular disease by lowering plasma homocysteine levels. This has led the US Food and Drug Administration to introduce fortification of bread, flour and rice with folic acid.